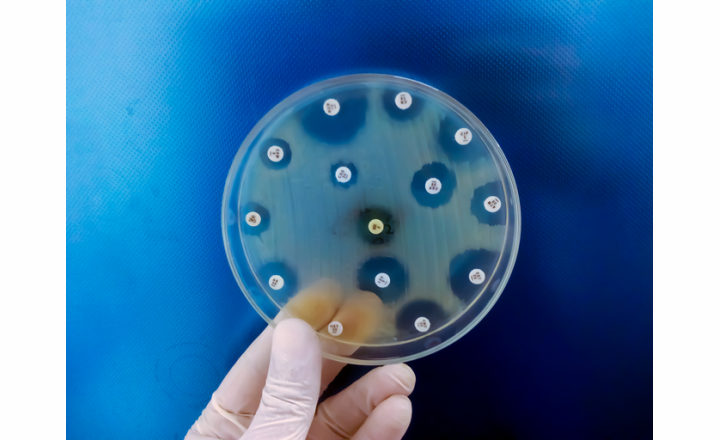
Intracellular Bacterial Persister Cells Contribute to Antibiotic Failure

Why this matters:
- Intracellular bacterial persister cells — metabolically dormant bacteria residing within host cells — contribute to antibiotic treatment failure, relapse, and chronic infection due to their tolerance to antibiotics.
- Traditional antibiotics often target actively dividing bacteria; persisters evade this by entering low-metabolic states induced by the host intracellular environment (acidification, oxidative stress, nutrient limitation).
- A host-directed strategy (rather than a new antibiotic) offers a complementary therapeutic path: by altering the host cell compartment to wake up or sensitize persisters, existing antibiotics can be repurposed more effectively. This has broad implications for tackling chronic, relapsing, or hard-to-treat infections caused by intracellular bacteria.
Key findings: The authors developed a high-throughput intracellular assay using macrophages infected with clinical S. aureus isolates and screened >4,700 drug-like compounds for those that increase bacterial metabolic activity without exhibiting host toxicity. The lead compound, K1, was further tested:
- KL1 did not promote bacterial outgrowth, was non-cytotoxic, but sensitized intracellular S. aureus persisters to antibiotic killing with rifampicin and moxifloxacin by up to 10-fold.
- KL1 enhanced antibiotic efficacy in macrophage infected with S. Typhimurium and M. tuberculosis.
- KL1 improved outcomes in murine models of S. aureus bacteremia and S. Typhimurium intracellular infection.
- Using a murine Salmonella infection model, a small but significant reduction in bacterial burden was reported for Peyer’s patches at 2 and 6 days post treatment when antibiotics were combined with KL1.
- Transcriptomic and biochemical analyses revealed that KL1 modulates host gene expression (immune response pathways) and suppresses host ROS/RNS production, alleviating one of the major stressors driving bacterial metabolic dormancy and antibiotic tolerance.
Bigger picture: This paper opens a promising therapeutic paradigm: host-directed adjuvants used in combination with antibiotics to clear intracellular, tolerant bacterial reservoirs. If the approach translates clinically, it could shorten treatment durations, reduce relapse rates, and curb the evolution of resistance emerging from persister reservoirs. Challenges remain - including defining optimal dosing, ensuring specificity, managing off-target host effects, and navigating regulatory pathways for adjuvant therapies. Nevertheless, the study provides a robust proof-of-concept that altering the host niche can re-sensitize hard-to-treat bacterial populations and extend the utility of existing antibiotics.
References:
1. Lu et al. (2025). “A host-directed adjuvant sensitizes intracellular bacterial persisters to antibiotics.” Nature Microbiology, 10.1038/s41564-025-02124-2.